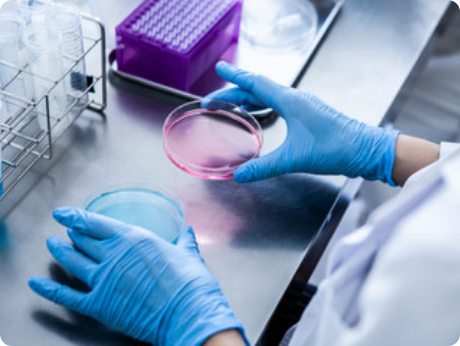

採用情報
ミツカンを知る
- 環境への取り組み
- ZENB initiative
- MIM(ミツカンミュージアム)
-
各部門が大切にしていること
-
おいしさと健康への取り組み
「買う身になって まごころこめて よい品を」お届けしたい。
そのための挑戦を、私たちは続けています。
ミツカングループの歴史は、酒粕を使ってお酢をつくるという挑戦からはじまりました。以来、時代や環境に合わせて、さまざまな事業の創出と改廃を行ないながら、常に変革と挑戦を忘れず続けてきたことが、いまのミツカングループをかたちづくってきました。
210余年の間、常に変わり続けてきたミツカングループ。しかしその根底にあったのはいつも変わらぬひとつの思いでした。それは、「買う身になって まごころこめて よい品を」お届けしたいという思いであり、私たちはこれからもそのための挑戦を続けていきたいと考えています。
この挑戦の姿勢を継続し、育てていくことこそがミツカングループの大きな使命なのです。
各採用サイトはこちらから
労働施策総合推進法に基づく
キャリア採用比率の公表
株式会社 Mizkan J plus Holdings
正規雇用労働者の
キャリア採用比率
2023
年度
37%
2024
年度
23%
2025
年度
6.7%
公表日:2026年3月18日
株式会社 Mizkan
正規雇用労働者の
キャリア採用比率
2023
年度
62%
2024
年度
52%
2025
年度
23.3%
公表日:2026年3月18日
採用に関するお問い合わせ
〒104-0033 東京都中央区新川1-22-15 茅場町中埜ビル
ミツカングループ人事本部
TEL:03-3555-2609
※受付:平日9:00~17:30